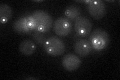

View description
Component of the spindle pole body outer plaque, required for exit from mitosis
Localization:
Intensity:
Fold change:
Significance:
-
C’ GFP library in SD
punctate22.37 -
N' NOP1pr-GFP in SD

punctate49.8587 -
N' TEF2pr-mCherry in SD

punctate46.1366 -
N' NATIVEpr-GFP in SD

punctate25.4477 -
N' TEF2pr-VC and Cyto-VN in SD

#N/A0 -
C’ GFP library in SD+DTT

punctate24.981.11No -
C’ GFP library in SD+H2O2

punctate18.770.83No -
C’ GFP library in Starvation Media

punctate23.321.04No -
C’ GFP library on the background of Pup2-DaMP

N/A -
C’ GFP library on the background of CCT mutant

N/A0N/AYes
